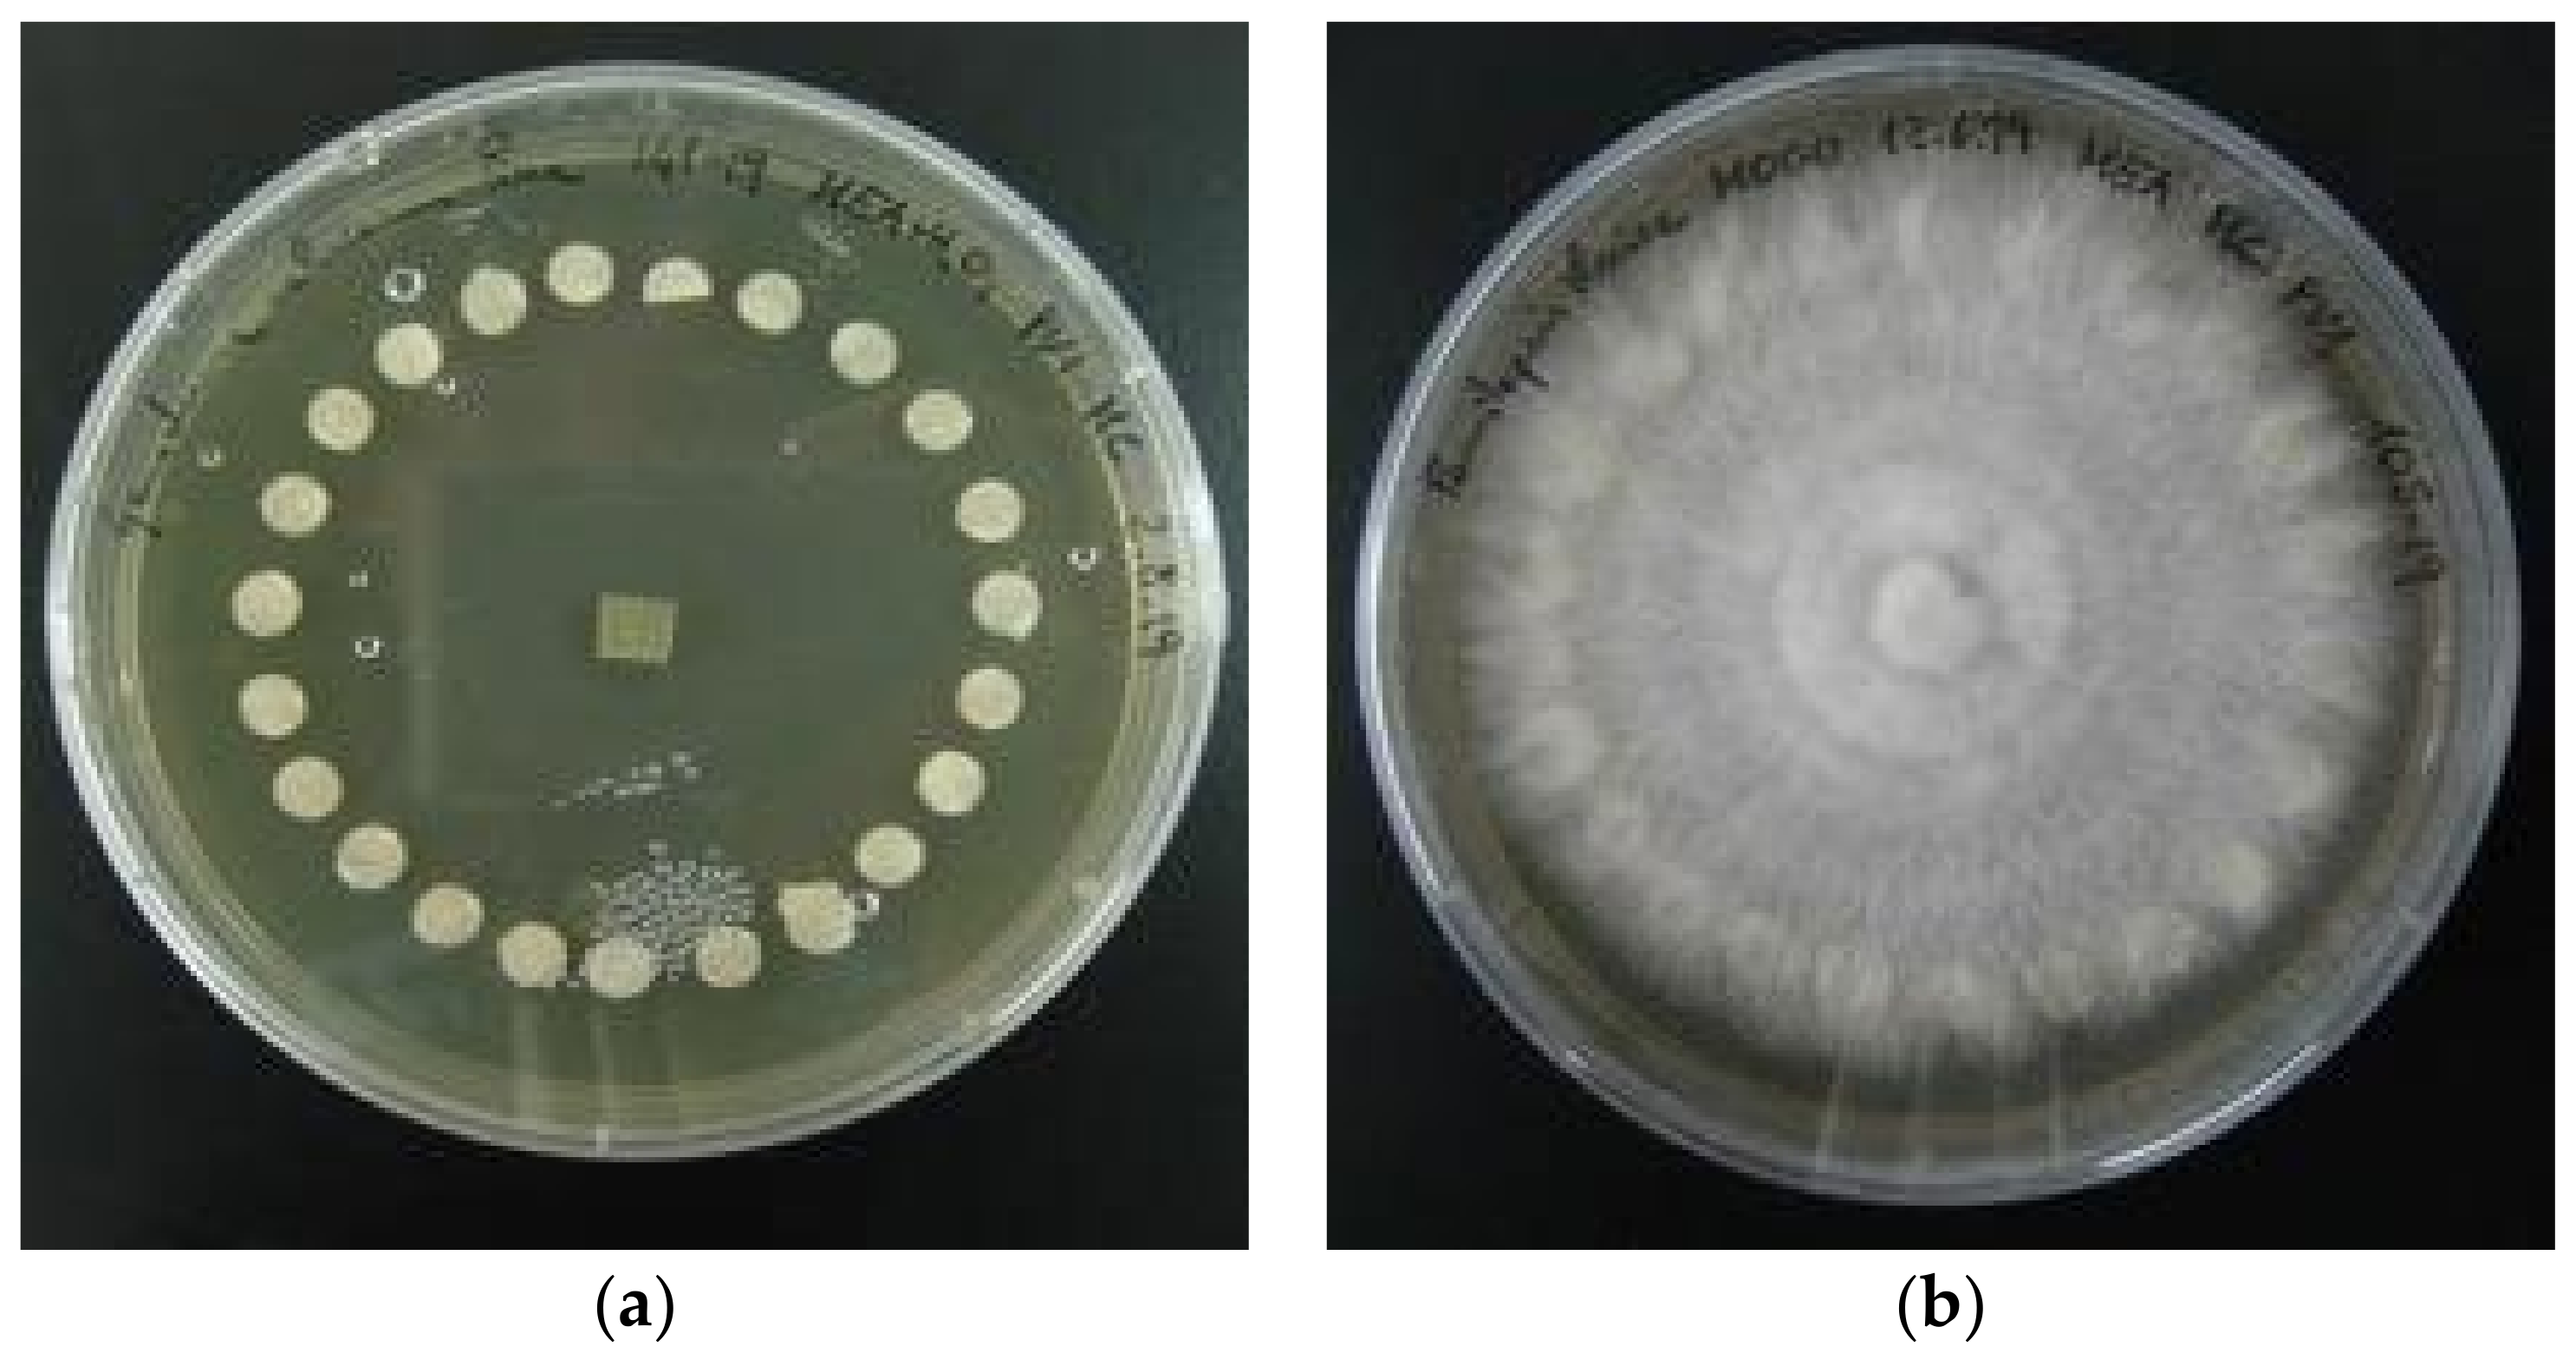
Diversity 14 00413 g001
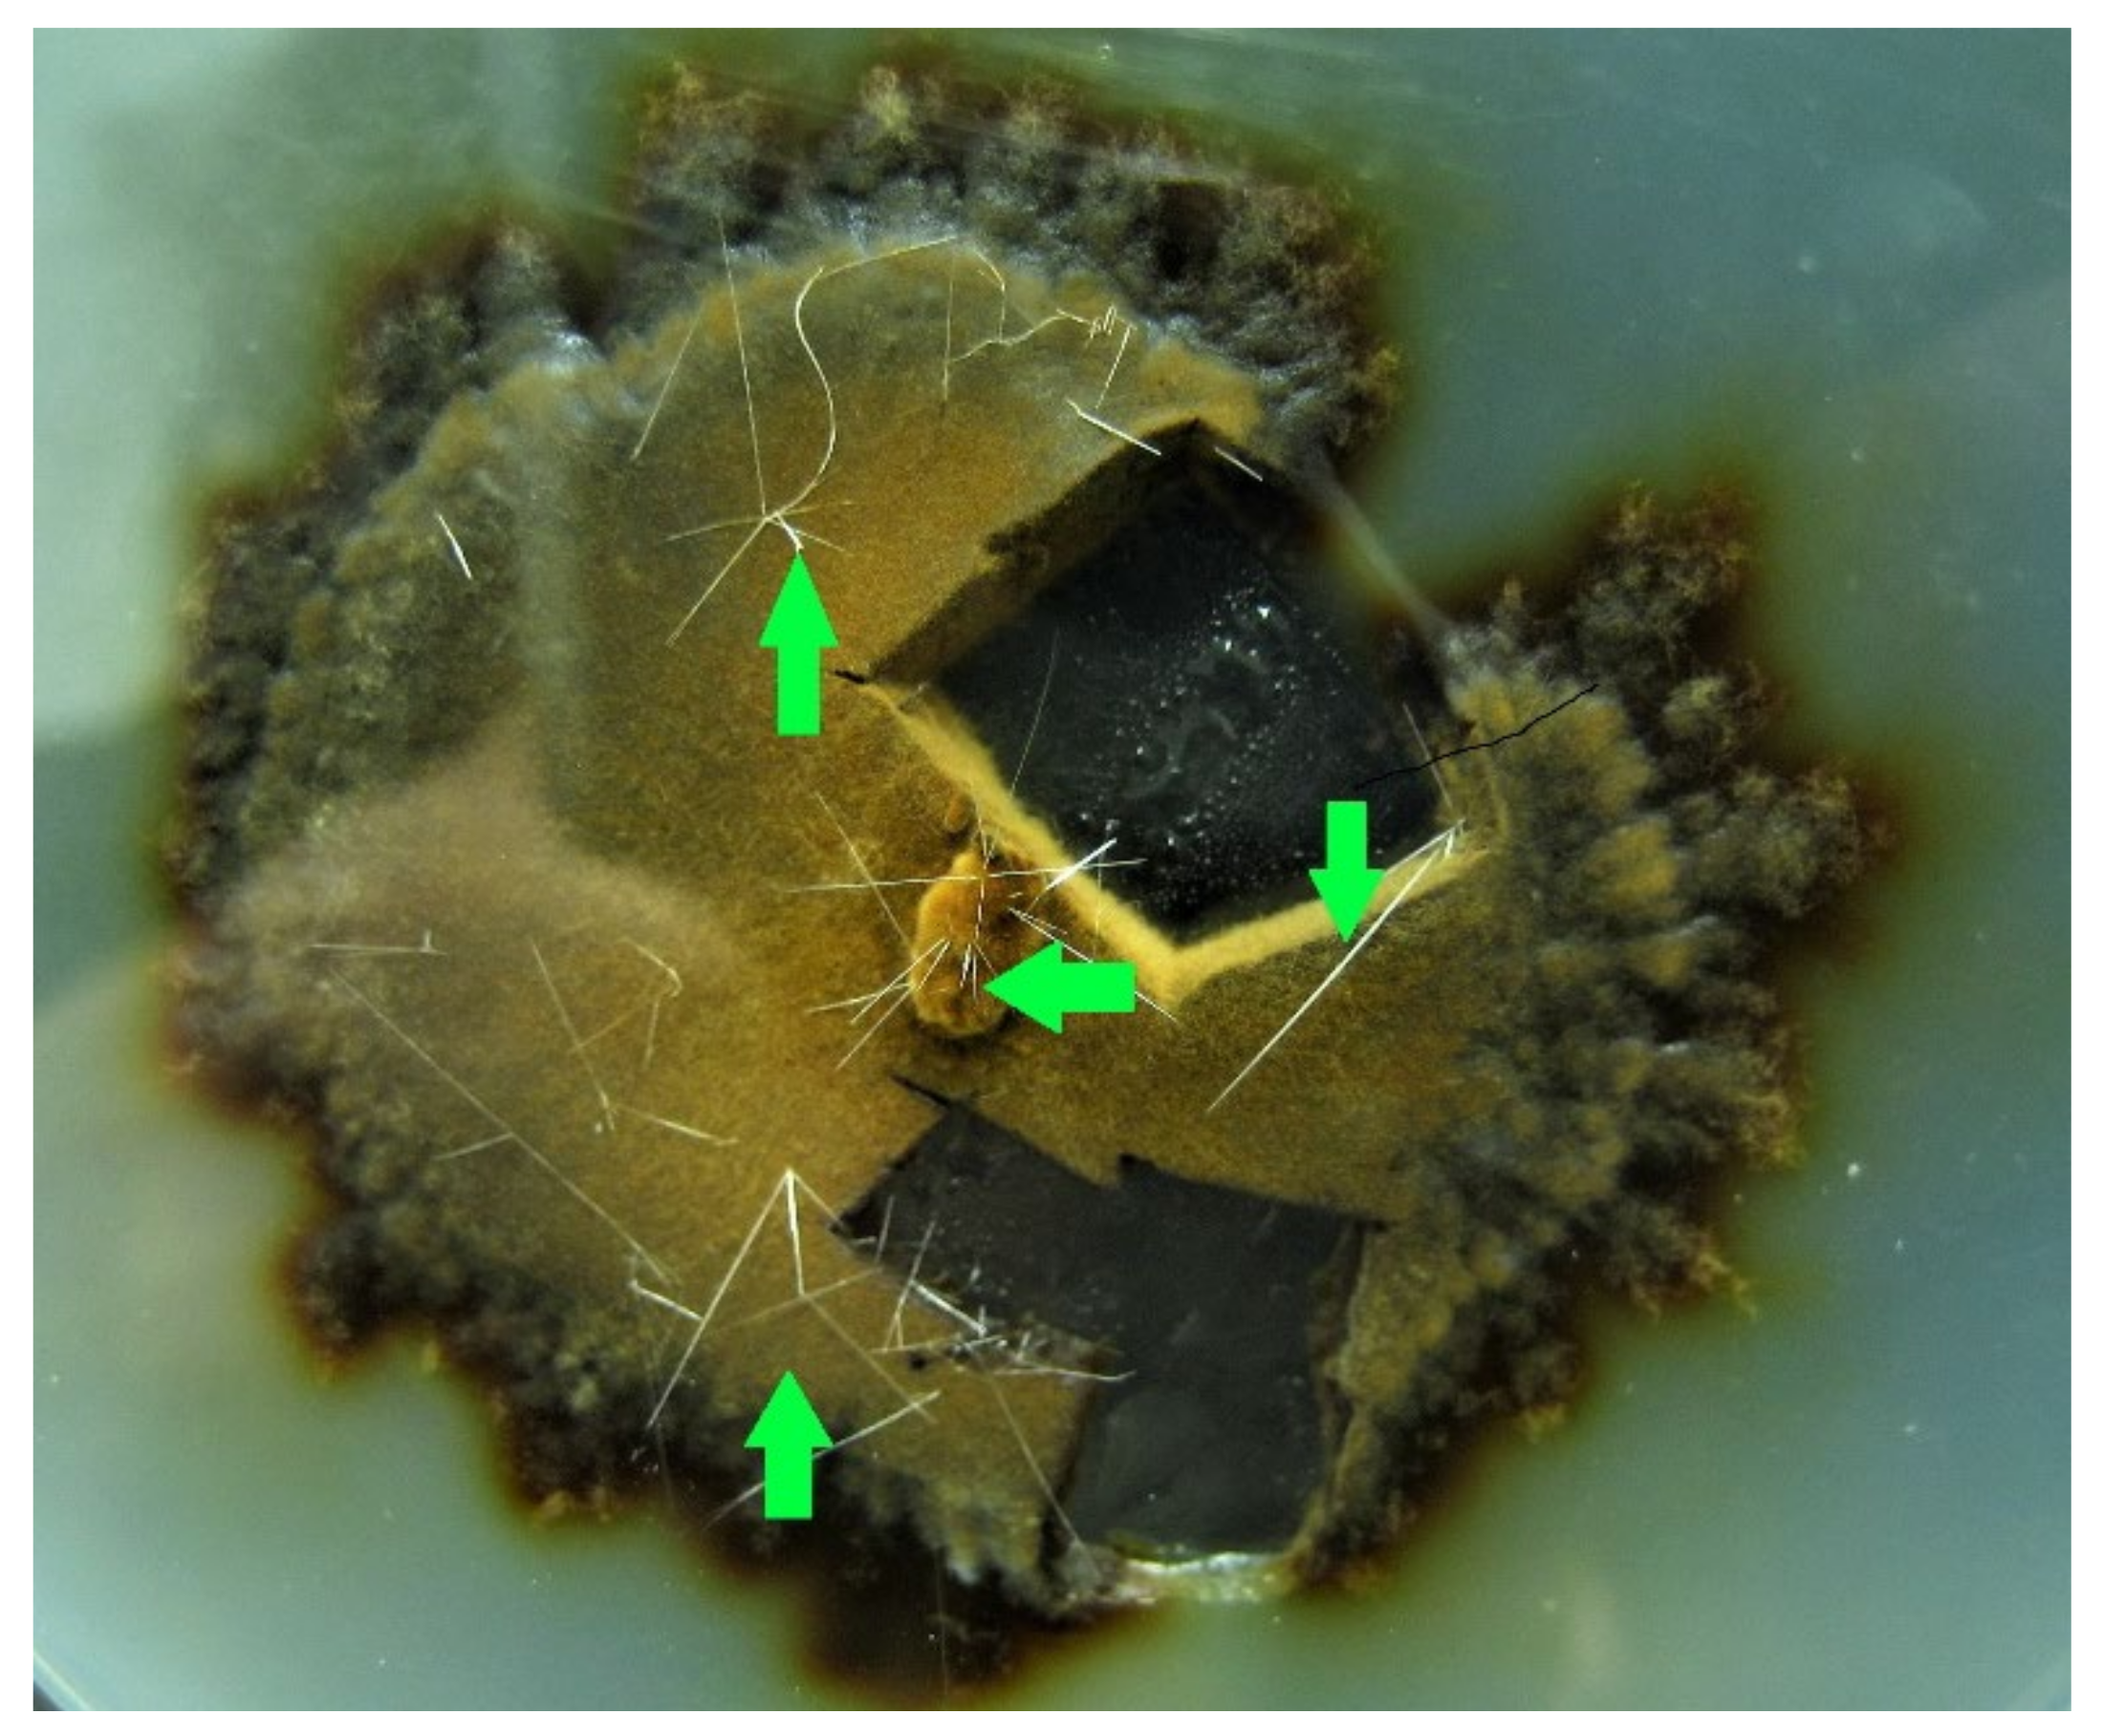
Diversity 14 00413 g006
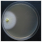
Diversity 14 00413 i002
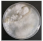
Diversity 14 00413 i006
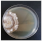
Diversity 14 00413 i011
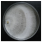
Diversity 14 00413 i025
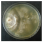
Diversity 14 00413 i030
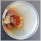
Diversity 14 00413 i034
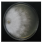
Diversity 14 00413 i043
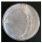
Diversity 14 00413 i045
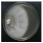
Diversity 14 00413 i056
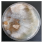
Diversity 14 00413 i058
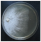
Diversity 14 00413 i060
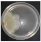
Diversity 14 00413 i062
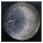
Diversity 14 00413 i066

Lignicolous Fungi Collected in Northern Italy: Identification and Morphological Description of Isolates
Abstract
:1. Introduction
2. Materials and Methods
2.1. Basidiomata Sampling
2.2. Fungal Strains Isolation
2.3. Basidiomata and Fungal Strains Identification
2.4. Fungal Strain Conservation
2.4.1. Conservation on Paper Discs
2.4.2. Cryoconservation
2.5. Morphological Description of Pure Cultures
3. Results
3.1. Basidiomata Sampling
3.2. Fungal Strains Collection
3.3. Basidiomata and Fungal Strains Identification
3.4. Morphological Description of Pure Cultures
- -
- Phylloporia ribis showed thin, up to 1 cm long, crystals. The nature of these peculiar structures is unknown and could be worthy of further investigation (Figure 6);
- -
- The brown rot agents Gloeophyllum odoratum, Neolentinus lepideus, Fomitopsis officinalis, Antrodia cfr. Alpina and Fomitopsis iberica and the white rot agents Fuscoporia contigua and Polyporus squamosus produced a non-localized MEA colour change to darker hues;
- -
- Neolentinus lepideus pure cultures developed a strong and pleasant anisate smell, similar to the basidiomata;
- -
- Abortiporus biennis and Peniophora quercina produced dark-reddish exudates.
3.5. Fungal Strains Conservation
4. Conclusions
Author Contributions
Funding
Institutional Review Board Statement
Data Availability Statement
Acknowledgments
Conflicts of Interest
References
- Hyde, K.D.; Xu, J.; Rapior, S.; Jeewon, R.; Lumyong, S.; Niego, A.G.T.; Abeywickrama, P.D.; Aluthmuhandiram, J.V.S.; Brahamanage, R.S.; Brooks, S.; et al. The amazing potential of fungi: 50 ways we can exploit fungi industrially. Fungal Divers. 2019, 97, 1–136. [Google Scholar] [CrossRef] [Green Version]
- Girometta, C.E.; Bernicchia, A.; Baiguera, R.M.; Bracco, F.; Buratti, S.; Cartabia, M.; Picco, A.M.; Savino, E. An Italian Research Culture Collection of Wood Decay Fungi. Diversity 2020, 12, 58. [Google Scholar] [CrossRef] [Green Version]
- WFCC—World Federation for Culture Collections. Available online: www.wfcc.info (accessed on 29 December 2021).
- CBS-KNAW Collections. Available online: www.cbs.knaw.nl (accessed on 29 December 2021).
- All Russian Collection of Microorganisms—VKM. Available online: www.vkm.ru (accessed on 29 December 2021).
- MIRRI—Microbial Resorurce Research Infrastructure. Available online: www.mirri.org (accessed on 29 December 2021).
- Stackebrandt, E.; Schüngel, M.; Martin, D.; Smith, D. The microbial resource research infrastructure MIRRI: Strength through coordination. Microorganisms 2015, 3, 890–902. [Google Scholar] [CrossRef] [Green Version]
- Gargano, M.L. Mycotheca of edible and medicinal mushrooms at herbarium SAF as a potential source of nutraceuticals and cultivated mushrooms. Int. J. Med. Mushrooms 2018, 20, 405–409. [Google Scholar] [CrossRef] [PubMed]
- Zotti, M.; Persiani, A.M.; Ambrosio, E.; Vizzini, A.; Venturella, G.; Donnini, D.; Angelini, P.; Di Piazza, S.; Pavarino, M.; Lunghini, D.; et al. Macrofungi as ecosystem resources: Conservation versus exploitation. Plant Biosyst. Int. J. Deal. All Asp. Plant Biol. 2013, 147, 219–225. [Google Scholar] [CrossRef] [Green Version]
- Varese, G.C.; Angelini, P.; Bencivenga, M.; Buzzini, P.; Donnini, D.; Gargano, M.L.; Maggi, O.; Pecoraro, L.; Persiani, A.M.; Savino, E.; et al. Ex situ conservation and exploitation of fungi in Italy. Plant Biosyst. 2011, 145, 997–1005. [Google Scholar] [CrossRef]
- Savino, E.; Girometta, C.E.; Chinaglia, S.; Guglielminetti, M.; Rodolfi, M.; Bernicchia, A.; Perini, C.; Salerni, E.; Picco, A.M. Medicinal mushrooms in Italy and their ex situ conservation through culture collection. In Proceedings of the 8th International Conference on Mushroom Biology and Mushroom Products (ICMBMP8), New Delhi, India, 19–22 November 2014. [Google Scholar]
- Doria, E.; Altobelli, E.; Girometta, C.E.; Nielsen, E.; Zhang, T.; Savino, E. Evaluation of lignocellulolytic activities of ten fungal species able to degrade poplar wood. Int. Biodeterior. Biodegrad. 2014, 94, 160–166. [Google Scholar] [CrossRef]
- Baldrian, P.; Gabriel, J. Intraspecific variability in growth response to cadmium of the wood-rotting fungus Piptoporus betulinus. Mycologia 2002, 94, 428–436. [Google Scholar] [CrossRef]
- Pawlik, A.; Janusz, G.; Dębska, I.; Siwulski, M.; Frąc, M.; Rogalski, J. Genetic and metabolic intraspecific biodiversity of Ganoderma lucidum. BioMed Res. Int. 2015, 2015, 726149. [Google Scholar] [CrossRef] [Green Version]
- Zeng, Z.; Sun, H.; Vainio, E.J.; Raffaello, T.; Kovalchuk, A.; Morin, E.; Duplessis, S.; Asiegbu, F.O. Intraspecific comparative genomics of isolates of the Norway spruce pathogen (Heterobasidion parviporum) and identification of its potential virulence factors. BMC Genom. 2018, 19, 220. [Google Scholar] [CrossRef] [Green Version]
- Corana, F.; Cesaroni, V.; Mannucci, B.; Baiguera, R.M.; Picco, A.M.; Savino, E.; Ratto, D.; Perini, C.; Kawagishi, H.; Girometta, C.E.; et al. Array of Metabolites in Italian Hericium erinaceus Mycelium, Primordium, and Sporophore. Molecules 2019, 24, 3511. [Google Scholar] [CrossRef] [PubMed] [Green Version]
- Dai, Y.C.; Yang, Z.L.; Cui, B.K.; Yu, C.J.; Zhou, L.W. Species diversity and utilization of medicinal mushrooms and fungi in China. Int. J. Med. Mushrooms 2009, 11, 287–302. [Google Scholar] [CrossRef]
- Vaidya, J.G.; Lamrood, P.Y. Traditional medicinal mushrooms and fungi of India. Int. J. Med. Mushrooms 2000, 2, 209–214. [Google Scholar] [CrossRef]
- Blasi, C.; Capotorti, G.; Copiz, R.; Guida, D.; Mollo, B.; Smiraglia, D.; Zavattero, L. Classification and mapping of the ecoregions of Italy. Plant Biosyst.-Int. J. Deal. All Asp. Plant Biol. 2014, 148, 1255–1345. [Google Scholar] [CrossRef]
- Sutherland, W.J. Ecological Census Techniques: A Handbook; Cambridge University Press: Cambridge, UK, 2006. [Google Scholar]
- Girometta, C.E.; Rovelli, L.; Bracco, F.; Brescia, F.; Baiguera, R.M.; Chiatante, G.; Picco, A.M.; Savino, E. The Medicinal Wood-Decay Species Laricifomes officinalis in the Alpe Veglia–Alpe Devero Natural Park (Italian Alps): Spatial Analysis and Growth Tests of Pure Cultures. Acta Mycol. 2021, 56, 569. [Google Scholar] [CrossRef]
- Global Fungal Red List Initiative. Available online: http://iucn.ekoo.se/iucn/species_view/297501 (accessed on 2 January 2022).
- Stalpers, J.A. Identification of wood-inhabiting fungi in pure culture. Stud. Mycol. 1978, 16, 1–248. [Google Scholar]
- Stamets, P. Growing Gourmet and Medicinal Mushrooms, 3rd ed.; Ten Speed Press: Berkeley, CA, USA, 2000. [Google Scholar]
- Sturini, M.; Girometta, C.E.; Maraschi, F.; Savino, E.; Profumo, A. A preliminary investigation on Metal Bioaccumulation by Perenniporia fraxinea. Bull. Environ. Contam. Toxicol. 2017, 98, 508–512. [Google Scholar] [CrossRef]
- Rush Wayn, R. Growing Mushrooms—The easy way. In Home Mushroom Cultivation with Hydrogen Peroxide Volume I, 3rd ed.; 2001; Available online: https://pdfcoffee.com/2-growing-mushrooms-the-easy-way-home-mushroom-cultivation-with-hydrogen-peroxidepdf-pdf-free.html (accessed on 29 December 2021).
- Ryvarden, L.; Melo, I. Poroid Fungi of Europe, 2nd ed.; Fungiflora: Oslo, Norway, 2017. [Google Scholar]
- Bernicchia, A.; Gorjón, S.P. Corticiaceae; Candusso: Alassio, Italy, 2006. [Google Scholar]
- Bernicchia, A.; Gorjon, S.P. Polypores of the Mediterranean Region; Romar: Segrate, Italy, 2020. [Google Scholar]
- Rivoire, B. Polypores des France et d’Europe; MYCOPOLYDEV: Orliénas, France, 2020. [Google Scholar]
- Janh, H. Pilze die an Holz Waksen, 1st ed.; Busse: Herford, Germany, 1979. [Google Scholar]
- Breitenbach, J.; Kranzlin, F. Champignons de Suisse T2; Mykologia: Lucerne, Switzerland, 1986. [Google Scholar]
- Julich, W. Guida alla Determinazione dei Funghi Vol. 2, Aphyllophorales, Heterobasidiomycetes, Gasteromycetes, 1st ed.; Saturnia: Roncafort di Trento, Italy, 1989. [Google Scholar]
- Genebank NCBI. Available online: https://blast.ncbi.nlm.nih.gov (accessed on 2 January 2022).
- Mycobank CBS. Available online: www.mycobank.org (accessed on 2 January 2022).
- García-García, M.; Rocha-Zavaleta, L.; Valdez-Cruz, N.A.; Trujillo-Roldan, M.A. Conservation of the mycelia of the medicinal mushroom Humphreya coffeata (Berk.) Stey. in sterile distilled water. MethodsX 2014, 1, 19–22. [Google Scholar] [CrossRef]
- Cartabia, M.; Girometta, C.E.; Milanese, C.; Baiguera, R.M.; Buratti, S.; Branciforti, D.S.; Vadivel, D.; Girella, A.; Babbini, S.; Savino, E.; et al. Collection and Characterization of Wood Decay Fungal Strains for Developing Pure Mycelium Mats. J. Fungi 2021, 7, 1008. [Google Scholar] [CrossRef]
- Harris, D.C. Quantitative Chemical Analysis, 7th ed.; W. H. Freeman and Company: New York, NY, USA, 2007. [Google Scholar]
- Cervini, M.; Gabba, G.; Macchi, P. Censimento dei Funghi Della Provincia di Varese; Nicolini Editore: Varese, Italy, 2000. [Google Scholar]
- Index Fungorum. Available online: http://www.indexfungorum.org/ (accessed on 2 January 2022).
- Spirin, V.; Runnel, K.; Vlasák, J.; Miettinen, O.; Põldmaa, K. Species diversity in the Antrodia crassa group (Polyporales, Basidiomycota). Fungal Biol. 2015, 119, 1291–1310. [Google Scholar] [CrossRef] [Green Version]
- Justo, A.; Miettinen, O.; Floudas, D.; Ortiz-Santana, B.; Sjökvist, E.; Lindner, D.; Nakasone, K.; Niemelä, T.; Larsson, K.H.; Ryvarden, L.; et al. A revised family-level classification of the Polyporales (Basidiomycota). Fungal Biol. 2017, 121, 798–824. [Google Scholar] [CrossRef] [PubMed]
- Moncalvo, J.M.; Wang, H.F.; Hseu, R.S. Gene phylogeny of the Ganoderma lucidum complex based on ribosomal DNA sequences. Comparison with traditional taxonomic characters. Mycol. Res. 1995, 99, 1489–1499. [Google Scholar] [CrossRef]
- Hong, S.G.; Jung, H.S. Phylogenetic analysis of Ganoderma based on nearly complete mitochondrial small-subunit ribosomal DNA sequences. Mycologia 2004, 96, 742–755. [Google Scholar] [CrossRef] [PubMed]
- Vizzini, A.; Angelini, C.; Ercole, E. Le sezioni Velatae e Aporus di Agrocybe sottogenere Aporus: Rivalutazione del genere Cyclocybe Velen. ed una nuova specie. RMR 2014, 92, 21–38. [Google Scholar]
- Onofri, S. Checklist of Italian Fungi–Basidiomycota; Carlo Delfino Editore: Sassari, Italy, 2005. [Google Scholar]
- Landingin, H.R.R.; Francisco, B.E.; Dulay, R.M.R.; Kalaw, S.; Reyes, R. Optimization of culture conditions for mycelial growth and basidiocarp production of Cyclocybe cylindracea (Maire). CLSU Int. J. Sci. Technol. 2020, 4, 1–17. [Google Scholar] [CrossRef]
- Nobles, M.K. Studies in forest pathology: VI. Identification of cultures of wood-rotting fungi. Can. J. Res. 1948, 26, 281–431. [Google Scholar] [CrossRef]
- Petre, C.V.; Tanase, C. Culture characteristics of 20 lignicolous basidiomycetes species that synthesize volatile organic compounds. Analele Stiintifice ale Universitatii" Al. I. Cuza" din Iasi 2013, 59, 37. [Google Scholar]
- Badalyan, S.M.; Shnyreva, A.V.; Iotti, M.; Zambonelli, A. Genetic resources and mycelial characteristics of several medicinal polypore mushrooms (Polyporales, Basidiomycetes). Int. J. Med. Mushrooms 2015, 17, 371–384. [Google Scholar] [CrossRef] [Green Version]
- Fischer, M. A new wood-decaying basidiomycete species associated with esca of grapevine: Fomitiporia mediterranea (Hymenochaetales). Mycol. Prog. 2002, 1, 315–324. [Google Scholar] [CrossRef]
- Balaeş, T.; Tănase, C. Description of in vitro cultures for some spontaneous lignicolous basidiomycetes species. Analele Ştiinţifice ale Universităţii “Al.I.Cuza” Iaşi s.II a Biologie Vegetală 2012, 58, 19–29. [Google Scholar]
- Buchalo, A.; Mykchaylova, O.; Lomberg, M.; Wasser, S.P. Microstructures of Vegetative Mycelium of Macromycetes in Pure Cultures; Alterpress: Kiev, Ukraine, 2009. [Google Scholar]
- Dresch, P.; Rosam, K.; Grienke, U.; Rollinger, J.M.; Peintner, U. Fungal strain matters: Colony growth and bioactivity of the European medicinal polypores Fomes fomentarius, Fomitopsis pinicola and Piptoporus betulinus. AMB Express 2015, 5, 4. [Google Scholar] [CrossRef] [PubMed] [Green Version]
- Petre, C.V.; Tănase, C. Description of the culture characteristics of some lignicolous basidiomycetes species grown on three synthetic media. J. Plant Dev. 2013, 20, 105–114. [Google Scholar]

| Ecoregional Section | Ecoregional Subsection | General Description of the Environment | Main Plant Species |
|---|---|---|---|
| Central and Eastern Alps | Pre-Alps | coniferous mixed forests | Pinus sylvestris, Quercus robur, Castanea sativa |
| Central and Eastern Alps | Pre-Alps | thermophilous broadleaf forest | Quercus pubescens, Cornus mas, Ostrya carpinifolia |
| Central and Eastern Alps | Pre-Alps | fresh broadleaved forests | Fagus sylvatica, Fraxinus excelsior, Carpinus betulus, Quercus robur, Robinia pseudoacacia |
| Western Alps | North-Western Alps | mountain forest | Picea abies, Abies alba, Larix decidua, Salix spp., Sorbus montanus and Alnus alnobetula |
| Italian part of Ligurian-Provencal Province | Italian part of Ligurian-Provencal Province | Mediterranean scrub | Quercus ilex, Myrtus communis, Pistacia lentiscus |
| Central and Eastern Alps | Pre-Alps | urban and suburban environments (tree lined roads, parks, private and public gardens) | Not applicable |
| Order | Family | Species | MRFC Code |
|---|---|---|---|
| Agaricales | Mycenaceae | Panellus stipticus (Bull.) P. Karst. | 183-21 |
| Strophariaceae | Cyclocybe cylindracea (DC.) Vizzini & Angelini | 187-21 | |
| Gloeophyllales | Gloeophyllaceae | Gloeophyllum odoratum (Wulfen) Imazeki | 077-18 |
| Neolentinus lepideus (Fr.) Redhead & Ginns | 132-19 | ||
| Neolentinus schaefferi (Weinm.) | 190-21 | ||
| Hymenochaetales | Hymenochaetaceae | Fomitiporia mediterranea M. Fisch. | 079-18 |
| Fomitiporia mediterranea M. Fisch. | 082-19 | ||
| Fuscoporia contigua (Pers.) G. Cunn. | 085-19 | ||
| Fuscoporia contigua (Pers.) G. Cunn. | 130-19 | ||
| Fuscoporia torulosa (Pers.) T. Wagner & M. Fisch. | 063-18 | ||
| Inonotus radiatus (Sowerby) P. Karst. | 053-18 | ||
| Phylloporia ribis (Schumach.) Ryvarden | 049-18 | ||
| Polyporales | Dacryobolaceae | Postia tephroleuca (Fr.) Julich | 211-21 |
| Fomitopsidaceae | Antrodia sp. | 074-18 | |
| Antrodia cfr. alpina (Litsch.) Gilb. & Ryvarden | 134-19 | ||
| Cyanosporus alni Niemelä & Vampola | 071-18 | ||
| Daedalea quercina (L.) Pers. | 089-19 | ||
| Flavidoporia pulvinascens (Pilát) Audet | 193-21 | ||
| Fomitopsis betulina (Bull.) B.K. Cui, M.L. Han & Y.C. Dai | 042-18 | ||
| Fomitopsis iberica Melo & Ryvarden | 004-18 | ||
| Fomitopsis iberica Melo & Ryvarden | 104-19 | ||
| Fomitopsis officinalis (Vill.) Bondartsev & Singer | 143-19 | ||
| Fomitopsis pinicola (Sw.) P. Karst. | 087-19 | ||
| Fomitopsis pinicola (Sw.) P. Karst. | 117-19 | ||
| Fomitopsis pinicola (Sw.) P. Karst. | 124-19 | ||
| Neoantrodia serialis (Fr.) Audet | 111-19 | ||
| Niveoporofomes spraguei (Berk. & M.A. Curtis) B.K. Cui, M.L. Han & Y.C. Dai | 156-19 | ||
| Osteina obducta (Berk.) Donk | 147-19 | ||
| Osteina undosa (Peck) B.K. Cui, L.L. Shen & Y.C. Dai | 162-19 | ||
| Grifolaceae | Grifola frondosa (Dicks.) Grey. | 210-21 | |
| Incrustoporiaceae | Skeletocutis amorpha (Fr.) Kotl. & Pouzar | 171-19 | |
| Tyromyces chioneus (Fr.) P. Karst. | 158-19 | ||
| Irpicaceae | Irpex lacteus (Fr.) Fr. | 076-18 | |
| Irpex lacteus (Fr.) Fr. | 160-19 | ||
| Irpex latemarginatus (Durieu & Mont.) C.C. Chen & Sheng H. Wu | 109-19 | ||
| Ischnodermataceae | Iscnoderma benzoinum (Wahlenb.) P. Karst. | 195-21 | |
| Laetiporaceae | Laetiporus sulphureus (Bull.) Murrill | 188-21 | |
| Phaeolus schweinitzii (Fr.) Pat. | 136-19 | ||
| Meruliaceae | Abortiporus biennis (Bull.) Singer | 064-18 | |
| Bjerkandera adusta (Willd.) P. Karst. | 101-19 | ||
| Vitreoporus dichrous (Fr.) Zmitr. | 083-19 | ||
| Phlebia rufa (Pers.) M.P. Christ. | 186-21 | ||
| Phanerochaetaceae | Antrodiella faginea Vampola & Pouzar | 169-19 | |
| Porostereum spadiceum (Pers.) Hjortstam & Ryvarden | 102-19 | ||
| Terana caerulea (Schrad. ex Lam.) Kuntze | 177-19 | ||
| Polyporaceae | Cerrena unicolor (Bull.) Murrill | 145-19 | |
| Coriolopsis gallica (Fr.) Ryvarden | 086-19 | ||
| Coriolopsis trogii (Berk.) Domanski | 027-18 | ||
| Daedaleopsis confragosa (Bolton) J. Schröt. | 155-19 | ||
| Daedaleopsis tricolor (Bull.) Bondartsev & Singer | 028-18 | ||
| Daedaleopsis tricolor (Bull.) Bondartsev & Singer | 148-19 | ||
| Dichomitus campestris (Quél.) Domanski & Orlicz | 168-19 | ||
| Dichomitus squalens (P. Karst.) D.A. Reid | 012-18 | ||
| Fomes fomentarius (L.) Fr. | 066-18 | ||
| Fomes fomentarius (L.) Fr. | 091-19 | ||
| Fomes fomentarius (L.) Fr. | 179-19 | ||
| Ganoderma adspersum (Schulzer) Donk | 106-19 | ||
| Ganoderma adspersum (Schulzer) Donk | 007-18 | ||
| Ganoderma adspersum (Schulzer) Donk | 036-18 | ||
| Ganoderma adspersum (Schulzer) Donk | 097-19 | ||
| Ganoderma adspersum (Schulzer) Donk | 112-19 | ||
| Ganoderma applanatum (Pers.) Pat. | 045-18 | ||
| Ganoderma carnosum Pat. | 161-19 | ||
| Ganoderma carnosum Pat. | 191-21 | ||
| Ganoderma lucidum (Curtis) P. Karst. | 037-19 | ||
| Ganoderma lucidum (Curtis) P. Karst. | 137-19 | ||
| Ganoderma resinaceum Boud. | 046-18 | ||
| Ganoderma resinaceum Boud. | 120-19 | ||
| Ganoderma resinaceum Boud. | 209-21 | ||
| Ganoderma valesiacum Boud. | 196-21 | ||
| Irpiciporus pachyodon (Pers.) Kotl. & Pouzar | 175-19 | ||
| Lenzites betulinus (L.) Fr. | 088-19 | ||
| Perenniporia fraxinea (Bull.) Ryvarden | 122-19 | ||
| Picipes melanopus (Pers.) Zmitr. & Kovalenko | 159-19 | ||
| Polyporus alveolaris (DC.) Bondartsev & Singer | 096-19 | ||
| Polyporus badius (Pers.) Schwein. | 093-19 | ||
| Polyporus corylinus Mauri | 192-21 | ||
| Polyporus squamosus (Huds.) Fr. | 094-19 | ||
| Pycnoporus cinnabarinus (Jacq.) P. Karst. | 174-19 | ||
| Sarcoporia polyspora P. Karst. | 172-19 | ||
| Trametes gibbosa (Pers.) Fr. | 054-18 | ||
| Trametes hirsuta (Wulfen) Pilát | 067-18 | ||
| Trametes hirsuta (Wulfen) Pilát | 144-19 | ||
| Trametes suaveolens (L.) Fr. | 061-18 | ||
| Trametes suaveolens (L.) Fr. | 070-18 | ||
| Trametes versicolor (L.) Lloyd | 139-19 | ||
| Trichaptum abietinum (Pers. ex J.F. Gmel.) Ryvarden | 133-19 | ||
| Truncospora atlantica Spirin & Vlasák | 078-18 | ||
| Yuchengia narymica (Pilát) B.K. Cui, C.L. Zhao & Steffen | 176-19 | ||
| Russulales | Bondarzewiaceae | Heterobasidion abietinum Niemelä & Korhonen | 069-18 |
| Heterobasidion annosum (Fr.) Bref. | 065-18 | ||
| Hericiaceae | Laxitextum bicolor (Pers.) Lentz | 166-19 | |
| Peniophoraceae | Peniophora quercina (Pers.) Cooke | 090-19 | |
| Stereaceae | Stereum hirsutum (Willd.) Pers. | 073-18 | |
| Stereum sanguinolentum (Alb. & Schwein.) Fr. | 127-19 |
| Species | MRFC Code | Mycelium Description | Average Growth Rate (mm day−1) | Colony Morphology on MEA (2%) | References |
|---|---|---|---|---|---|
| Abortiporus biennis (Bull.) Singer | 064-18 | Colony colour white. Colony edge appressed, edge line fringed, marginal hyphae fimbriate. Mat cottony. Aerial mycelium < 1.5–5 µm wide, submerged mycelium < 1.5–3 µm wide. Clamps present. Chlamydospores present. | 8.1 | ![]() | [23] |
| Antrodia alpina (Litsch.) Gilb. & Ryvarden | 134-19 | Colony colour white to yellowish-ochraceous. Reverse darkened. Colony edge appressed, edge line fringed, marginal hyphae fimbriate. Mat downy-felty. Aerial mycelium 1.5–3 µm wide, submerged mycelium < 1.5–3 µm wide. Clamps absent. Anastomosis present. | 0.7 | ![]() | |
| Antrodiella faginea Vampola & Pouzar | 169-19 | Colony uncoloured to white. Reverse bleached. Colony edge submerged to appressed, edge line fringed, marginal hyphae fimbriate. Mat farinaceous-velvety. Aerial mycelium 1.5–3 µm wide, submerged mycelium < 1.5–3 µm wide. Clamps absent. | 1.4 | ![]() | |
| Bjerkandera adusta (Willd.) P. Karst. | 101-19 | Colony white. Reverse bleached. Colony edge appressed to raised, edge line fringed, marginal hyphae fimbriate. Mat cottony-woolly-floccose. Aerial mycelium 3–5 µm wide. Clamps present. | 10.3 | ![]() | [23] |
| Cerrena unicolor (Bull.) Murrill | 145-19 | Colony white. Colony edge raised, edge line fringed, marginal hyphae fimbriate. Mat woolly-floccose. Aerial mycelium 1.5–3 µm wide, submerged mycelium 3–5 µm wide. Clamps absent. | 8.3 | ![]() | [23] |
| Coriolopsis gallica (Fr.) Ryvarden | 086-19 | Colony uncoloured to white. Colony edge appressed, edge line fringed, marginal hyphae fimbriate. Mat felty. Aerial mycelium < 1.5–3 µm wide. Clamps present. | 4.9 | ![]() | [23] |
| Coriolopsis trogii (Berk.) Domanski | 027-18 | Colony colour white to cream. Colony edge raised, edge line fringed, marginal hyphae fimbriate. Mat silky to felty. Aerial mycelium < 1.5–5 µm wide, submerged mycelium < 1.5–5 µm wide. Clamps present. | 4.8 | ![]() | [23] |
| Cyanosporus alni Niemelä & Vampola | 071-18 | Colony uncoloured. Colony edge appressed to raised, edge line compact, marginal hyphae dense. Mat downy. Submerged mycelium 1.5–3 µm wide. Clamps absent. | 0.3 | ![]() | |
| Cyclocybe cylindracea (DC.) Vizzini & Angelini | 187-21 | Colony white to brownish. Colony edge raised, edge line fringed, marginal hyphae fimbriate. Mat silky-woolly. Aerial mycelium < 1.5–5 µm wide. Clamps present. | 3.3 | ![]() | [47] |
| Daedalea quercina (L.) Pers. | 089-19 | Colony white to cream. Colony edge appressed to raised, edge line fringed, marginal hyphae fimbriate. Mat felty. Aerial mycelium < 1.5–3 µm wide. Clamps present. | 3.0 | ![]() | [23,48] |
| Daedaleopsis confragosa (Bolton) J. Schröt. | 155-19 | Colony white to brown. Reverse darkened. Colony edge appressed to raised, edge line compact, marginal hyphae dense. Mat woolly-floccose, zonated. Aerial mycelium 1.5–3 µm wide, submerged mycelium 3–5 µm wide. Clamps present. | 3.1 | ![]() | [23,48,49] |
| Daedaleopsis tricolor (Bull.) Bondartsev & Singer | 148-19 | Colony white to brown. Colony edge appressed, edge line fringed, marginal hyphae fimbriate. Mat cottony. Aerial mycelium 1.5–3 µm wide. Clamps absent. | 5.2 | ![]() | [49] |
| Dichomitus campestris (Quél.) Domanski & Orlicz | 168-19 | Colony white. Colony edge raised, edge line fringed, marginal hyphae fimbriate. Mat downy, zonated. Aerial mycelium 1.5–3 µm wide, submerged mycelium 1.5–7.5 µm wide. Clamps present. | 1.9 | ![]() | |
| Dichomitus squalens (P. Karst.) D.A. Reid | 012-18 | Colony white-cream. Colony edge appressed to raised, edge line fringed, marginal hyphae fimbriate. Mat floccose-felty. Aerial mycelium 1.5–3 µm wide. Clamps present. Chlamydospores present. | 5.4 | ![]() | [23] |
| Flavidoporia pulvinascens (Pilát) Audet | 193-21 | Colony uncoloured to white. Colony edge raised, edge line fringed, marginal hyphae fimbriate. Mat woolly. Aerial mycelium 3–7.5 µm wide, submerged mycelium 1.5–3 µm wide. Clamps present. | 0.7 | ![]() | |
| Fomes fomentarius (L.) Fr. | 179-19 | Colony white. Colony edge appressed to raised, edge line fringed, marginal hyphae fimbriate. Mat woolly-felty. Aerial mycelium 1.5–3 µm wide, submerged mycelium 1.5–3. Clamps present. | 6.6 | ![]() | [23,48,49,50] |
| Fomitiporia mediterranea M. Fisch. | 079-18 | Colony yellowish-ochraceous. Colony edge raised, edge line fringed, marginal hyphae fimbriate. Mat cottony, zonated. Aerial mycelium < 1.5–3 µm wide, submerged mycelium 3–5. Clamps absent. Hyphae with some oil drops. | 2.30 | ![]() | [51] |
| Fomitopsis betulina (Bull.) B.K. Cui, M.L. Han & Y.C. Dai | 042-18 | Colony white. Colony edge appressed, edge line fringed, marginal hyphae fimbriate. Mat woolly-floccose. Aerial mycelium 1.5–5 µm wide, submerged mycelium 1.5–3 µm wide. Clamps present. | 4.4 | ![]() | [23,48] |
| Fomitopsis iberica Melo & Ryvarden | 104-19 | Colony white. Colony edge raised, edge line fringed, marginal hyphae fimbriate. Mat silky-floccose. Aerial mycelium < 1.5–3 µm wide, submerged mycelium 1.5–3 µm wide. Clamps present. Hyphae with some oil drops. Chlamidospores present, but rare. | 6.0 | ![]() | |
| Fomitopsis officinalis (Vill.) Bondartsev & Singer | 143-19 | Colony white. Reverse bleached. Colony edge appressed, edge line fringed, marginal hyphae fimbriate. Mat woolly-floccose-plumose. Aerial mycelium 1.5–3 µm wide, submerged mycelium 1.5–3 µm wide. Clamps present. Chlamydospores present. | 1.3 | ![]() | [23,48] |
| Fomitopsis pinicola (Sw.) P. Karst. | 117-19 | Colony white. Colony edge raised, edge line fringed, marginal hyphae fimbriate. Mat woolly-floccose. Aerial mycelium < 1.5–5 µm wide. Clamps present. | 3.5 | ![]() | [23,48,49,50] |
| Fuscoporia contigua (Pers.) G. Cunn. | 085-19 | Colony brownish. Colony edge appressed, edge line compact, marginal hyphae dense. Mat silky-crustose. Aerial mycelium 1.5–5 µm wide. Clamps absent. | 0.9 | ![]() | [23] |
| Fuscoporia torulosa (Pers.) T. Wagner & M. Fisch. | 063-18 | Colony yellowish. Reverse darkened. Colony edge appressed, edge line fringed, marginal hyphae fimbriate. Mat cottony. Aerial mycelium 1.5–5 µm wide, submerged mycelium 1.5–5 µm wide. Clamps absent. Mycelium with skeletal hyphae. | 0.3 | ![]() | [23] |
| Ganoderma adspersum (Schulzer) Donk | 036-18 | Colony white to yellow-ochraceous. Reverse bleached. Colony edge appressed, edge line fringed, marginal hyphae fimbriate. Mat downy. Aerial mycelium < 1.5–5 µm wide. Clamps present. Mycelium with skeletal hyphae and oil drops. | 3.7 | ![]() | [23,50] |
| Ganoderma applanatum (Pers.) Pat. | 045-18 | Colony white. Reverse bleached. Colony edge appressed, edge line fringed, marginal hyphae fimbriate. Mat silky-velvety-crustose. Aerial mycelium 3–5 µm wide. Clamps present. Saline crystals present. | 4.8 | ![]() | [23,48,50] |
| Ganoderma carnosum Pat. | 161-19 | Colony white to yellowish-ochraceous. Reverse bleached. Colony edge appressed, edge line fringed, marginal hyphae fimbriate. Mat cottony-floccose-crustose. Aerial mycelium 1.5–3 µm wide, submerged mycelium 1.5–3 µm wide. Clamps present. Saline crystals present. | 4.8 | ![]() | |
| Ganoderma lucidum (Curtis) P. Karst. | 137-19 | Colony white. Reverse bleached. Colony edge appressed, edge line fringed, marginal hyphae fimbriate. Mat cottony. Submerged mycelium 1.5–3 µm wide. Clamps present. | 2.6 | ![]() | [23,48,50,52,53] |
| Ganoderma resinaceum Boud. | 046-18 | Colony white. Reverse bleached. Colony edge raised, edge line fringed, marginal hyphae fimbriate. Mat farinaceous. Aerial mycelium < 1.5–3 µm wide, submerged mycelium < 1.5–3 µm wide. Clamps present. Chlamidospores abundant. Anastomosis present. | 7.5 | ![]() | [23,50] |
| Ganoderma valesiacum Boud. | 196-21 | Colony white-ochraceous. Colony edge appressed, edge line fringed to bayed, marginal hyphae fimbriate. Mat downy-farinaceous. Aerial mycelium <1.5–5 µm wide, submerged mycelium <1.5–3 µm wide. Clamps present. | 0.8 | ![]() | |
| Gloeophyllum odoratum (Wulfen) Imazeki | 077-18 | Colony white-cream. Reverse darkened. Colony edge appressed-raised, edge line fringed, marginal hyphae fimbriate. Mat downy-woolly. Aerial mycelium 1.5–5 µm wide, submerged mycelium 1.5–3 µm wide. Clamps present. | 0.2 | ![]() | [23] |
| Grifola frondosa (Dicks.) Grey. | 210-21 | Colony white. Colony edge raised, edge line fringed, marginal hyphae fimbriate. Mat cottony-woolly. Aerial mycelium < 1.5–3 µm wide, submerged mycelium 1.5–3 µm wide. Clamps present. | 3.2 | ![]() | [23,48,53] |
| Heterobasidion abietinum Niemelä & Korhonen | 069-18 | Colony white-yellowish. Colony edge raised, edge line fringed, marginal hyphae fimbriate. Mat farinaceous-granular to floccose. Aerial mycelium 1.5–7.5 µm wide. Clamps absent. Chlamidospores present. Numerous basidia. | 2.4 | ![]() | |
| Heterobasidion annosum (Fr.) Bref. | 065-18 | Colony white to yellow-ochraceous. Colony edge submerged, edge line fringed, marginal hyphae fimbriate. Mat silky-floccose. Aerial mycelium < 1.5–5 µm wide, submerged mycelium < 1.5–7.5 µm wide. Clamps absent. Chlamidospores present. | 1.3 | ![]() | [23,48] |
| Inonotus radiatus (Sowerby) P. Karst. | 053-18 | Colony brownish. Colony edge submerged, edge line fringed, marginal hyphae bayed. Mat downy. Aerial mycelium 1.5–5 µm wide, submerged mycelium 1.5–3 µm wide. Clamps absent. Hyphae with oil drops. | 1.1 | ![]() | [23,48] |
| Irpex lacteus (Fr.) Fr. | 076-18 | Colony white. Reverse bleached. Colony edge raised, edge line fringed, marginal hyphae fimbriate. Mat silky-woolly. Aerial mycelium 1.5–7.5 µm wide, submerged mycelium 1.5–7.5 µm wide. Clamps absent. Mycelium with skeletal hyphae. | 8.0 | ![]() | [23] |
| Irpex latemarginatus Durieu & Mont. | 109-19 | Colony white. Colony edge raised, edge line fringed, marginal hyphae fimbriate. Mat cottony to floccose. Aerial mycelium 1.5–3 µm wide, submerged mycelium 3–5 µm wide. Clamps absent. Hyphae with oil drops. Anastomosis present. | 9.8 | ![]() | [23] |
| Irpiciporus pachyodon (Pers.) Kotl. & Pouzar | 175-19 | Colony white. Reverse bleached. Colony edge appressed to raised, edge line fringed, marginal hyphae fimbriate. Mat cottony to floccose. Aerial mycelium < 1.5–5 µm wide. Clamps present. Skeletal hyphae present. Chlamidospores present. | 4.5 | ![]() | [23] |
| Ischnoderma benzoinum (Wahlenb.) P. Karst. | 195-21 | Colony uncoloured to white. Colony edge appressed to submerged, edge line fringed, marginal hyphae fimbriate-bayed. Mat downy-velvety. Aerial mycelium 1.5–3 µm wide, submerged mycelium 1.5–3 µm wide. Clamps present. | 3.3 | ![]() | [23] |
| Laetiporus sulphureus (Bull.) Murrill | 188-21 | Colony cream. Colony edge appressed to submerged, edge line fringed, marginal hyphae fimbriate. Mat farinaceous-granular-floccose. Aerial mycelium 1.5–5 µm wide, submerged mycelium 5–7 µm wide. Chlamydospores abundant. | 2.6 | ![]() | [23,48,53] |
| Laxitextum bicolor (Pers.) Lentz | 166-19 | Colony white-cream. Reverse darkened. Colony edge appressed to raised, edge line fringed, marginal hyphae fimbriate. Mat woolly-floccose to farinaceous. Aerial mycelium 1.5–3 µm wide, submerged mycelium < 1.5–7 µm wide. Clamps present. Mycelium with skeletal hyphae. | 3.4 | ![]() | [23] |
| Lenzites betulinus (L.) Fr. | 088-19 | Colony white. Colony edge raised, edge line fringed, marginal hyphae fimbriate. Mat cottony-floccose to felty. Aerial mycelium 1.5–3 µm wide, submerged mycelium 1.5–3 µm wide. Clamps present. | 3.1 | ![]() | [23,48,54] |
| Neoantrodia serialis (Fr.) Audet | 111-19 | Colony uncoloured to white. Reverse bleached. Colony edge appressed, edge line fringed, marginal hyphae fimbriate. Mat downy-cottony-floccose. Aerial mycelium < 1.5–3 µm wide, submerged mycelium 1.5–3 µm wide. Clamps absent. Saline crystals present. Hyphae with some oil drops. | 2.3 | ![]() | [23,48] |
| Neolentinus lepideus (Fr.) Redhead & Ginns | 132-19 | Colony white. Reverse darkened. Colony edge appressed to submerged, edge line fringed, marginal hyphae fimbriate. Mat cottony-woolly-felty. Aerial mycelium 1.5–3 µm wide, submerged mycelium < 1.5 µm wide. Clamps present. | 3.3 | ![]() | [48] |
| Neolentinus schaefferi (Weinm.) Redhead & Ginns | 190-21 | Colony white. Reverse darkened. Colony edge appressed to raised, edge line even, marginal hyphae dense. Mat farinaceous. Aerial mycelium < 1.5–3 µm wide, sumberged mycelium 1.5–3 µm wide. Clamps present. Chlamydospores present. Hyphae with oil drops. | 2.5 | ![]() | |
| Niveoporofomes spraguei (Berk. & M.A. Curtis) B.K. Cui, M.L. Han & Y.C. Dai | 156-19 | Colony white. Colony edge raised, edge line fringed, marginal hyphae fimbriate. Mat cottony-floccose. Aerial mycelium 1.5–3 µm wide, submerged mycelium 3–5 µm wide. Clamps present but scarce. Chlamidospores abundant. | 3.1 | ![]() | |
| Osteina obducta (Berk.) Donk | 147-19 | Colony uncoloured to slight brownish. Colony edge appressed, edge line fringed, marginal hyphae fimbriate. Mat absent to downy. Aerial mycelium < 1.5–7 µm wide, submerged mycelium < 1.5–3 µm wide. Clamps present. | 0.3 | ![]() | [23] |
| Osteina undosa (Peck) B.K. Cui, L.L. Shen & Y.C. Dai | 162-19 | Colony uncoloured. Colony edge raised, edge line fringed, marginal hyphae fimbriate. Mat downy. Aerial mycelium 1.5–3 µm wide, submerged mycelium 1.5–3 µm wide. Clamps present. | 0.2 | ![]() | |
| Panellus stipticus (Bull.) P. Karst. | 183-21 | Colony white. Reverse bleached. Colony edge appressed, edge line fringed, marginal hyphae fimbriate. Mat downy-cottony-floccose. Aerial mycelium < 1.5–3 µm wide, submerged mycelium 1.5–3 µm wide. Clamps absent. Saline crystals present. Hyphae with oil drops. | 1.5 | ![]() | |
| Peniophora quercina (Pers.) Cooke | 090-19 | Colony white. Reverse bleached. Colony edge submerged-appressed, edge line fringed, marginal hyphae fimbriate. Mat downy to cottony-woolly-floccose. Aerial mycelium 3–5 µm wide, submerged mycelium 1.5–3 µm wide. Clamps present. Saline crystals present. | 4.0 | ![]() | [23] |
| Perenniporia fraxinea (Bull.) Ryvarden | 122-19 | Colony white, with a pink gradient. Reverse bleached. Colony edge appressed, edge line fringed, marginal hyphae fimbriate. Mat cottony-felty. Aerial mycelium 1.5–3 µm wide, submerged mycelium 1.5–3 µm wide. Clamps present. Chlamidospores present. | 3.4 | ![]() | [23,48] |
| Phaeolus schweinitzii (Fr.) Pat. | 136-19 | Colony yellowish-ochraceous. Reverse darkened. Colony edge appressed, edge line fringed, marginal hyphae fimbriate. Mat woolly-floccose. Aerial mycelium 1.5–5 µm wide. Clamps present. | 2.4 | ![]() | [23,48] |
| Phlebia rufa (Pers.) M.P. Christ. | 186-21 | Colony white-cream. Colony edge appressed to submerged, edge line fringed, marginal hyphae fimbriate. Mat woolly-floccose-plumose. Aerial mycelium 1.5–3 µm wide. Clamps present. Saline crystals present. | 8.5 | ![]() | [23] |
| Phylloporia ribis (Schumach.) Ryvarden | 049-18 | Colony yellow-ochraceous. Reverse darkened. Colony edge raised, edge line compact, marginal hyphae fimbriate. Mat cottony. Aerial mycelium 1.5–3 µm wide. Clamps absent. Anastomosis present. | 0.1 | ![]() | [23] |
| Picipes melanopus (Pers.) Zmitr. & Kovalenko | 159-19 | Colony white. Reverse bleached. Colony edge appressed, edge line fringed, marginal hyphae fimbriate. Mat cottony-woolly-floccose. Aerial mycelium 1.5–3 µm wide, submerged mycelium 1.5–5 µm wide. Clamps present. Saline crystals present. | 0.7 | ![]() | [23] |
| Polyporus alveolaris (DC.) Bondartsev & Singer | 096-19 | Colony white. Reverse bleached. Colony edge appressed to submerged, edge line fringed, marginal hyphae fimbriate. Mat cottony-woolly. Aerial mycelium 1.5–3 µm wide, submerged mycelium 1.5–3 µm wide. Clamps present. Saline crystals present. | 4.3 | ![]() | [23,48] |
| Polyporus badius (Pers.) Schwein. | 093-19 | Colony white. Colony edge appressed to submerged, edge line fringed, marginal hyphae dense. Mat downy to cottony-woolly. Aerial mycelium 1.5–3 µm wide, submerged mycelium 1.5–3 µm wide. Clamps absent. | 3.0 | ![]() | [23] |
| Polyporus corylinus Mauri | 192-21 | Colony white. Reverse bleached. Colony edge raised, edge line fringed, marginal hyphae fimbriate. Mat felty. Aerial mycelium < 1.5–3 µm wide, submerged mycelium < 1.5–3 µm wide. Clamps present. Chlamidospores abundant. | 4.9 | ![]() | |
| Polyporus squamosus (Huds.) Fr. | 094-19 | Colony white to brownish. Reverse bleached. Colony edge raised, edge line fringed, marginal hyphae fimbriate. Mat farinaceous-floccose. Aerial mycelium 3–5 µm wide, submerged mycelium 1.5–5 µm wide. Clamps present. | 1.1 | ![]() | [23,48,55] |
| Porostereum spadiceum (Pers.) Hjortstam & Ryvarden | 102-19 | Colony white. Reverse bleached. Colony edge raised, edge line fringed, marginal hyphae fimbriate. Mat plumose. Aerial mycelium <1.5–3 µm wide, submerged mycelium <1.5–3 µm wide. Clamps present. | 6.0 | ![]() | |
| Postia tephroleuca (Fr.) Julich | 211-21 | Colony white. Reverse bleached. Colony edge appressed, edge line fringed, marginal hyphae fimbriate to slighty bayed. Mat farinaceous-felty-velvety. Aerial mycelium 1.5–5 µm wide, sumberged mycelium 1.5–5 µm wide. Clamps present. Saline crystals present. | 1.2 | ![]() | [23] |
| Pycnoporus cinnabarinus (Jacq.) P. Karst. | 174-19 | Colony white to orange-reddish. Reverse bleached. Colony edge appressed to submerged, edge line fringed, marginal hyphae fimbriate. Mat woolly-velvety. Aerial mycelium 1.5–3 µm wide, sumberged mycelium 1.5–3 µm wide. Clamps present. | 4.3 | ![]() | [23,48] |
| Sarcoporia polyspora P. Karst. | 172-19 | Colony uncoloured to whitish. Colony edge appressed, edge line compact-bayed, marginal hyphae dense. Mat silky. Aerial mycelium 3–5 µm wide, sumberged mycelium 1.5–3 µm wide. Clamps present. | 0.3 | ![]() | |
| Skeletocutis amorpha (Fr.) Kotl. & Pouzar | 171-19 | Colony uncoloured. Colony edge appressed, edge line fringed-bayed, marginal hyphae fimbriate. Mat downy. Sumberged mycelium 5–7.5 µm wide. Clamps absent. | 0.2 | ![]() | [23,48] |
| Stereum hirsutum (Willd.) Pers. | 073-18 | Colony white to orange. Colony edge raised, edge line fringed, marginal hyphae fimbriate. Mat cottony-floccose. Aerial mycelium < 1.5–7.5 µm wide, sumberged mycelium < 1.5 µm wide. Clamps present. Skeletal hyphae present. | 9.6 | ![]() | [23,49,55] |
| Stereum sanguinolentum (Alb. & Schwein.) Fr. | 127-19 | Colony white to ochraceous. Colony edge raised, edge line fringed, marginal hyphae fimbriate-bayed. Mat downy. Sumberged mycelium 1.5–3 µm wide. Clamps rare. | 0.9 | ![]() | [23,48] |
| Terana caerulea (Schrad. ex Lam.) Kuntze | 177-19 | Colony white to blue. Reverse bleached. Colony edge appressed to submerged, edge line fringed, marginal hyphae fimbriate. Mat woolly-floccose. Aerial mycelium 3–7.5 µm wide. Clamps present. | 4.3 | ![]() | |
| Trametes gibbosa (Pers.) Fr. | 054-18 | Colony white. Colony edge appressed, edge line fringed, marginal hyphae fimbriate. Mat floccose. Aerial mycelium < 1.5–3 µm wide, sumberged mycelium < 1.5–3 µm wide. Clamps present. | 6.6 | ![]() | [23] |
| Trametes hirsuta (Wulfen) Pilát | 067-18 | Colony white to cream. Colony edge appressed to raised, edge line fringed, marginal hyphae fimbriate. Mat woolly-floccose. Aerial mycelium < 1.5–5 µm wide. Clamps present. | 4.7 | ![]() | [23,48,55] |
| Trametes suaveolens (L.) Fr. | 070-18 | Colony white. Reverse bleached. Colony edge appressed, edge line fringed, marginal hyphae fimbriate. Mat cottony-woolly-floccose. Aerial mycelium 1.5–3 µm wide. Clamps present. | 7.5 | ![]() | [23,48] |
| Trametes versicolor (L.) Lloyd | 139-19 | Colony white. Reverse bleached. Colony edge appressed to raised, edge line fringed, marginal hyphae fimbriate. Mat downy-floccose. Aerial mycelium < 1.5–3 µm wide, submerged mycelium < 1.5. Clamps present. | 6.9 | ![]() | [23,48,55] |
| Trichaptum abietinum (Pers. ex J.F. Gmel.) Ryvarden | 133-19 | Colony uncoloured. Colony edge appressed, edge line fringed, marginal hyphae fimbriate. Mat cottony. Aerial mycelium < 1.5–5 µm wide, sumberged mycelium < 1.5–3 µm wide. Clamps present. Chlamydospores present. | 0.9 | ![]() | |
| Truncospora atlantica Spirin & Vlasák | 078-18 | Colony white. Colony edge raised, edge line even, marginal hyphae dense. Mat farinaceous. Aerial mycelium < 1.5–3 µm wide, sumberged mycelium 1.5–3 µm wide. Clamps present. Chlamydospores present. Hyphae with oil drops. | 0.8 | ![]() | |
| Tyromyces chioneus (Fr.) P. Karst. | 158-19 | Colony white. Colony edge appressed, edge line fringed, marginal hyphae fimbriate. Mat cottony-floccose. Aerial mycelium 1.5–5 µm wide, sumberged mycelium 1.5–3 µm wide. Clamps present. | 2.7 | ![]() | |
| Yuchengia narymica (Pilát) B.K. Cui, C.L. Zhao & Steffen | 176-19 | Colony white. Reverse bleached. Colony edge appressed to raised, edge line fringed. Mat downy- farinaceous-granular to floccose-plumose. Aerial mycelium 1.5–5 µm wide, sumberged mycelium 1.5–3 µm wide. Clamps absent. Chlamydospores abundant. | 2.0 | ![]() | |
| Vitreoporus dichrous (Fr.) Zmitr. | 083-19 | Colony uncoloured. Colony edge submerged, edge line bayed, marginal hyphae fimbriate. Mat sumberged. Submerged mycelium 1.5–3 µm wide. Clamps present. | 3.8 | ![]() | [23,48] |
Publisher’s Note: MDPI stays neutral with regard to jurisdictional claims in published maps and institutional affiliations. |
© 2022 by the authors. Licensee MDPI, Basel, Switzerland. This article is an open access article distributed under the terms and conditions of the Creative Commons Attribution (CC BY) license (https://creativecommons.org/licenses/by/4.0/).
Share and Cite
Cartabia, M.; Girometta, C.E.; Baiguera, R.M.; Buratti, S.; Babbini, S.; Bernicchia, A.; Savino, E. Lignicolous Fungi Collected in Northern Italy: Identification and Morphological Description of Isolates. Diversity 2022, 14, 413. https://doi.org/10.3390/d14050413
Cartabia M, Girometta CE, Baiguera RM, Buratti S, Babbini S, Bernicchia A, Savino E. Lignicolous Fungi Collected in Northern Italy: Identification and Morphological Description of Isolates. Diversity. 2022; 14(5):413. https://doi.org/10.3390/d14050413
Chicago/Turabian StyleCartabia, Marco, Carolina Elena Girometta, Rebecca Michela Baiguera, Simone Buratti, Stefano Babbini, Annarosa Bernicchia, and Elena Savino. 2022. "Lignicolous Fungi Collected in Northern Italy: Identification and Morphological Description of Isolates" Diversity 14, no. 5: 413. https://doi.org/10.3390/d14050413
APA StyleCartabia, M., Girometta, C. E., Baiguera, R. M., Buratti, S., Babbini, S., Bernicchia, A., & Savino, E. (2022). Lignicolous Fungi Collected in Northern Italy: Identification and Morphological Description of Isolates. Diversity, 14(5), 413. https://doi.org/10.3390/d14050413